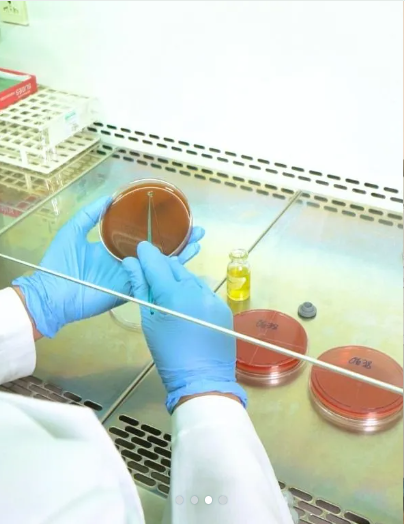

SERVICE AND FACILITIES
De La Salle UNIVERSITY Medical CENTER
DLSUMC operates under the stewardship of the De La Salle Brothers Philippines and is jointly administered by medical consultants and the Sisters of St. Paul de Chartres. Located within the 24-hectare campus of De La Salle Medical and Health Sciences Institute in Dasmariñas City, Cavite. As part of its vision, DLSUMC continuously upgrades its facilities and improves the delivery of healthcare services to the people of Cavite and its neighboring towns, cities, and provinces.
Medical Center
Nurturing Your Health
Academics
Nurturing Potentials
Research
Nurturing Discoveries
Medical Center
Nurturing Your Health
Academics
Nurturing Potentials
Research
Nurturing Discoveries
Lasallian Mission
Living the Mission
Lasallian Mission
Living the Mission
Medical Center
Nurturing Your Health
Academics
Nurturing Potentials
Research
Nurturing Discoveries
Lasallian Mission
Living the Mission
Medical Center
Nurturing Your Health
Academics
Nurturing Potentials
Research
Nurturing Discoveries
Lasallian Mission
Living the Mission
Medical Center
Nurturing Your Health
Academics
Nurturing Potentials
Research
Nurturing Discoveries
Lasallian Mission
Living the Mission
SERVICES AND FACILITIES
DE LA SALLE UNIVERSITY MEDICAL CENTER
SY 2024-2025
| POSITION | NAME |
|---|---|
| Vice Chancellor for Hospital Operations | Conrado P. Crisostomo, MD, FPOGS, FPSUOG, MHSA |
| Medical Director | Ardith Dominguez-Tan, MD, FPCP, FPCC, FPSE |
| Director, Centers of Excellence | Antonio P. Vytingco Jr., MD |
| Director, Hospital Administrative and Support Services | Gary N. Carlos, MD, FPCP, FPCCP |
| Director, Nursing Services | Sr. Michelle Cristy Fernandez, SPC |
| Assistant Medical Director / Chief of Clinics | Maria Concepcion Ortillo-General, MD, FPCS, FPSGS, FPATOS, MBAH |
| Associate Director, Centers of Excellence | Cynthia L. Capistrano |
| Associate Director, Hospital Administrative and Support Services | Pinky Rose S. Viloria, RND |
| Associate Director, Nursing Services | Leila J. Morte, RN |
Contact Us
OFFICE OF THE VICE CHANCELLOR FOR HOSPITAL OPERATIONS
Ground Floor, Building 1
De La Salle University Medical Center
De La Salle Medical and Health Sciences Institute
+63 (2) 8988-3100 (Manila)
+63 (46) 481-8000 (Cavite)
Local no.: 2100
PHONE
Governor D. Mangubat Avenue, Zone IV, City of Dasmariñas, Cavite, Philippines